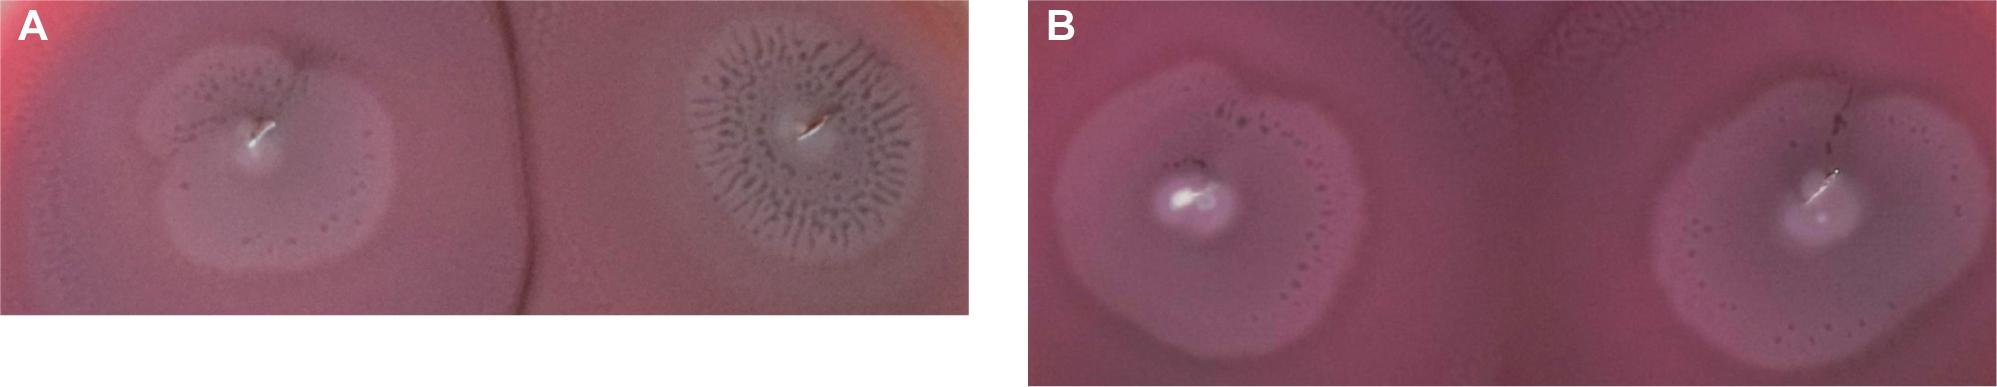

Fig. 1.
Fig. 2.

Genetic similarity of P_ mirabilis isolates (n = 26)_
Demographic and clinical parameters of patients with Proteus spp_ BSIs (n = 83)_
| Variable | Death in 14 days (n = 24) | Survival (n = 59) | p-value* | ||
|---|---|---|---|---|---|
| Age (years), median (min-max) | 77.5 (55–94) | 67.0 (12–88) | 0.0025** | ||
| Sex | Men, No. (%) | 13 (54.2) | 33 (55.9) | 0.9229 | |
| Women, No. (%) | 11 (45.8) | 26 (44.1) | |||
| Length of stay in hospital (days), median (min-max) | 19.5 (1–139) | 38 (5–406) | 0.0142** | ||
| Length of stay in hospital before Proteus spp. BSI (days), median (min-max) | 9.5 (0–138) | 7.5 (0–380) | 1.0000** | ||
| Primary bacteremia, No. (%) | 11 (45.8) | 23 (39.0) | 0.7420 | ||
| Secondary bacteremia, No. (%) | 13 (54.2) | 36 (61.0) | |||
| Adequate empiric antibiotic therapy, No. (%) | 16 (66.7) | 43 (72.9) | 0.7648 | ||
| More than one strain in blood culture, No. (%) | 9 (37.5) | 20 (34.0) | 0.9537 | ||
| ESBL Proteus spp., No. (%) | 4 (16.7) | 11 (18.6) | 0.9185 | ||
| Predisposing factors | Urinal catheter, No. (%) | 18 (75.0) | 44 (67.8) | 0.8117 | |
| Central Venus Catheter, No. (%) | 15 (62.5) | 28 (47.5) | 0.3168 | ||
| Diabetes, No. (%) | 7 (29.2) | 10 (16.9) | 0.3419 | ||
| Hospitalization during past half year, No. (%) | 13 (54.2) | 25 (42.4) | 0.4625 | ||
| Cancer, No. (%) | 3 (12.5) | 4 (6.8) | 0.6784 | ||
| Surgery during past half year, No. (%) | 9 (37.5) | 33 (55.9) | 0.2003 | ||
| Cardio-vascular diseases, No. (%) | 15 (62.5) | 23 (39.0) | 0.0879 | ||
| Chronic wounds, No. (%) | 7 (29.2) | 13 (22.0) | 0.6849 | ||
The strains isolated from patients with P_ mirabilis (n = 93) and P_ vulgaris (n = 5) bacteremia_
| Year | spp. bacteremia Protteus | Secondary Proteus spp. bacteremia | Isolation of Proteus spp. not related directly to bacteremia | ||||||||||||||
|---|---|---|---|---|---|---|---|---|---|---|---|---|---|---|---|---|---|
| Total | Source of secondary bacteremia (strains isolated at the time/up to three days before isolation from blood sample) | Before bacteremia (more than three days) | After bacteremia | ||||||||||||||
| Urinary tract | Respiratory tract | Wounds | Blood catheter | Peritoneum | Respiratory tract | Wounds | Urinary tract | Blood catheter | Peritoneum | Respiratory tract | Wounds | Urinary tract | Blood catheter | Peritoneum | |||
| 2009 | 12 | 8 (66.7%) | 7 | 1 | 0 | 0 | 0 | 1 | 0 | 2 | 0 | 0 | 0 | 1 | 1 | 0 | 0 |
| 2010 | 12 | 8 (66.7%) | 4 | 0 | 2 | 2 | 0 | 0 | 2 | 0 | 0 | 0 | 0 | 4 | 1 | 2 | 0 |
| 2011 | 7 | 4 (57.1%) | 1 | 0 | 2 | 0 | 1 | 0 | 2 | 0 | 1 | 1 | 0 | 0 | 1 | 0 | 0 |
| 2012 | 4 | 4 (100.0%) | 1 | 1 | 1 | 1 | 0 | 0 | 0 | 1 | 0 | 0 | 0 | 0 | 0 | 1 | 0 |
| 2013 | 14 | 8 (57.1%) | 2 | 2 | 2 | 2 | 0 | 3 | 2 | 1 | 0 | 0 | 0 | 2 | 0 | 1 | 1 |
| 2014 | 14 | 9 (64.3%) | 5 | 0 | 3 | 1 | 0 | 0 | 2 | 1 | 0 | 0 | 1 | 0 | 0 | 0 | 1 |
| 2015 | 9 | 4 (44.4%) | 1 | 1 | 2 | 0 | 0 | 0 | 0 | 0 | 0 | 0 | 1 | 1 | 1 | 0 | 0 |
| 2016 | 15 | 8 (53.3%) | 5 | 1 | 1 | 1 | 0 | 0 | 1 | 1 | 0 | 0 | 1 | 1 | 0 | 0 | 0 |
| 2017 | 11 | 5 (45.5%) | 1 | 2 | 1 | 0 | 1 | 0 | 0 | 1 | 0 | 0 | 2 | 2 | 1 | 1 | 0 |
| Total | 98 | 58 (59.2%) | 27 | 8 | 14 | 7 | 2 | 4 | 9 | 7 | 1 | 1 | 5 | 11 | 5 | 5 | 2 |
Antibacterial agents (Aas) susceptibility of Proteus spp_ strains (n = 98) isolated from bacteremia_
| Aas | Primary bacteremia Aas susceptibility | p* | Secondary bacteremia Aas susceptibility | Total Aas susceptibility | |||||||||||||||
|---|---|---|---|---|---|---|---|---|---|---|---|---|---|---|---|---|---|---|---|
| S | I | R | S | I | R | S | I | R | |||||||||||
| n | % | n | % | n | % | n | % | n | % | n | % | n | % | n | % | n | % | ||
| AMC | 9 | 22.5 | 24 | 60.0 | 7 | 17.5 | 0.4588 | 16 | 27.6 | 28 | 48.3 | 14 | 24.1 | 25 | 25.5 | 52 | 53.1 | 21 | 21.4 |
| TZP | 40 | 100.0 | 0 | 0.0 | 0 | 0.0 | 0.1316 | 54 | 93.1 | 0 | 0.0 | 4 | 6.9 | 94 | 95.9 | 0 | 0.0 | 4 | 4.1 |
| CMX | 28 | 70.0 | 0 | 0.0 | 12 | 30.0 | 0.6037 | 45 | 77.6 | 0 | 0.0 | 13 | 22.4 | 73 | 74.5 | 0 | 0.0 | 25 | 25.5 |
| CTX | 31 | 77.5 | 0 | 0.0 | 9 | 22.5 | 0.3393 | 46 | 79.3 | 0 | 0.0 | 12 | 20.7 | 77 | 78.6 | 0 | 0.0 | 21 | 21.4 |
| CAZ | 35 | 87.5 | 2 | 5.0 | 3 | 7.5 | 0.1697 | 51 | 87.9 | 0 | 0.0 | 7 | 12.1 | 86 | 87.8 | 2 | 2.0 | 10 | 10.2 |
| FEP | 32 | 80.0 | 2 | 5.0 | 6 | 15.0 | 0.4254 | 48 | 82.8 | 4 | 6.9 | 6 | 10.3 | 80 | 81.6 | 6 | 6.1 | 12 | 12.2 |
| IMP | 30 | 75.0 | 8 | 20.0 | 2 | 5.0 | 0.6062 | 49 | 84.5 | 8 | 13.8 | 1 | 1.7 | 79 | 80.6 | 16 | 16.3 | 3 | 3.1 |
| GEN | 29 | 72.5 | 1 | 2.5 | 10 | 25.0 | 0.3662 | 46 | 79.3 | 1 | 1.7 | 11 | 19.0 | 75 | 76.5 | 2 | 2.0 | 21 | 21.4 |
| AMK | 33 | 82.5 | 3 | 7.5 | 4 | 10.0 | 0.6311 | 52 | 89.7 | 4 | 6.9 | 2 | 3.4 | 85 | 86.7 | 7 | 7.1 | 6 | 6.1 |
| CIP | 24 | 60.0 | 1 | 2.5 | 15 | 37.5 | 0.4336 | 38 | 65.5 | 5 | 8.6 | 15 | 25.9 | 62 | 63.3 | 6 | 6.1 | 30 | 30.6 |
| SXT | 20 | 50.0 | 0 | 0.0 | 20 | 50.0 | 0.3165 | 28 | 48.3 | 0 | 0.0 | 30 | 51.7 | 48 | 49.0 | 0 | 0.0 | 50 | 51.0 |